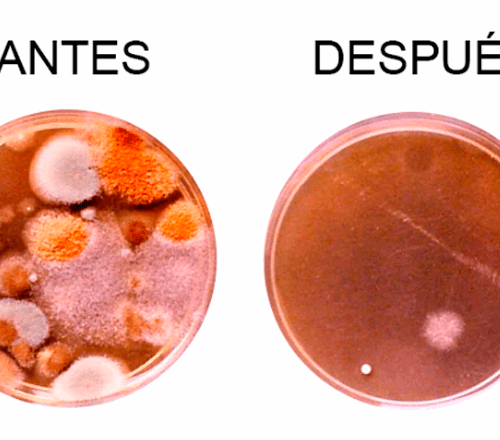

PURIFICADOR DE AIRE CAPS MINI
SISTEMA DE PURIFICACIÓN FOTOHIDROIONIZANTE COMERCIAL
CAPS-Mini probó reducir drásticamente olores generados internamente, hongos y bacterias por encima del 90%, junto con una significativa reducción del humo. Reducción del mismo nivel en grasas en suspensión y gases de mercurio + 90%. Un equipo portátil para utilizar en ambientes que no tienen AA y se quiere purificar el ambiente.
TECNOLOGÍA
CAPS-MINI utiliza la célula fotohidroionizante QR + de RGF. En esta célula la radiación generada por una lámpara UV incide sobre una superficie metálica en forma y revestimiento adecuados para actuar como catalizador en la formación de iones súperoxidantes, tales como el peróxido de hidrógeno.
MÁS CONFORT
Reduce los niveles de humo, hongos, olores y bacterias. Su tecnología elimina grasas y mercurio. Con su exclusivo sistema resulta un equipo, económico, con bajo costo de mantenimiento, cuenta con 10.000 horas de vida útil del PHI, es compacto y versátil.